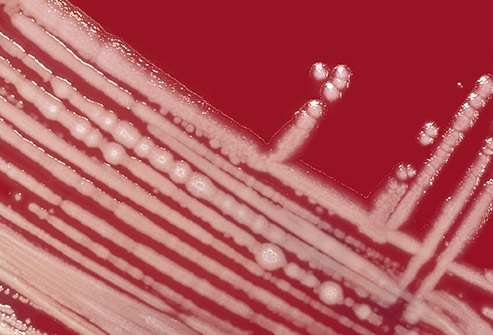
طفح الأنبوب الساخن

1. مشاكل الجهاز الهضمي:

إن التقطتَّ شيئاً ما في أثناء السباحة، فمن المُرجح أنَّك تعرَّضت للإصابة بطفيلي مثل "خفية الأبواغ" (الكريبتوسبوريديوم) أو "الجيارديا"، واللذان يُعدَّان المُتَّهمان الرئيسان في إحداث هذه المشاكل غالباً، ومن الممكن أيضاً أن تكون إصابتك ناتجة عن فيروس النورو أو جرثومة E.coli أو جرثومة الشيغيلا. لذا حاول من أجل حماية نفسك ألَّا تبتلع المياه في أثناء السباحة، ومن أجل حماية الأخرين ابق خارج المياه إن كنت مصاباً بالإسهال.
2. أُذُنُ السَّبَّاح:
إنَّ "أذن السبَّاح" هو المصطلح الطبي المُستخدم في وصف هذه الحالة "التهاب الأذن الخارجية"، ومن الشائع الإصابة به عند قضاء وقت طويل في أي نوع من المياه كانت؛ حيث يصبح الجلد سهل التمزق ضمن الوسط الرطب؛ ما يُسهل على الجراثيم الدخول واختراقه. يمكن للقطرات التي لا تحتاج وصفة طبية أن تقي من الإصابة، وفي حال أُصبت بهذا النوع من الالتهاب، سيتوجب عليك مراجعة الطبيب من أجل أخذ الصادَّات المناسبة.
3. داء الفيالقة أو حمّى الفيلق (داء الليجونيلا):

يمكنك أن تُصاب بهذا النوع من المرض (داء الفيالقة) عند استنشاقك هواءً يحوي العامل الممرض وهو جرثومة "الفيلقية المستروحة" (Legionella). يمكن لهذه الجرثومة أن تتواجد في أحواض الاستحمام الساخنة غير المنظفة جيداً وبالتالي يمكن أن تنتقل الجرثومة عبر استنشاق البخار في هذه الحالة. ويعدُّ داء الليجونيلا هو المرض الأشيع من بين الأمراض المنقولة عبر الماء في الولايات المتحدة.
4. طفح حمامات المياه الساخنة:
يمكن للبقاء فترة طويلة في مياه دافئة أن يُسبب ظهور بقع حمراء خشنة حاكَّة؛ وإنَّ العامل المسبب غالباً جرثومة العصيَّات الزرق أو ما يسمّى علمياً بالزائفة الزنجارية. من الصعب إبقاء منتجعات المياه المعدنية الساخنة نظيفة مقارنة بالمسابح؛ لأنَّ درجات الحرارة المرتفعة تُخرِّب مادة الكلور المُعقِّمة، ما يجعل هذه المنتجعات بيئة خصبة لهذه الأنواع من الجراثيم. حاول دائماً أن تستحم بالماء والصابون بعد المكوث في هذه الأمكنة، إضافة إلى غسل سترة سباحتك أيضاً.
5. الطحالب السامة:

قد تنمو في بعض الأحيان هذه النباتات الصغيرة الموجودة في المحيطات والمياه العذبة بشكل خارج عن السيطرة مُنتِجةً سموماً خطيرةً، وتُدعى هذه المشكلة البيئية بـ "تكاثر الطحالب الضارة" (HAB)، وهي منتشرة في جميع الولايات الأمريكية الموجودة على خط الساحل. تُدعى إحدى أنواع الطحالب بالبكتيريا الزرقاء؛ وتسبب الإسهال والطفح الجلدي ومشاكل الرئة.
لا تسبح في الأماكن التي تبدو رغوية، وانتبه إلى الملصقات التي تُحذِّر من تكاثر الطحالب الضارة (HAB).
6. حكة السباح:

يعتبر هذا الطفح الجلدي نوع من أنواع البلهارسيا، ويمكن أن تُصاب به عند السباحة في المياه العذبة أو المالحة، وهو ارتكاس طفيلي صغير يخترق الجلد. تبدأ الإصابة به من الحلزونات المصابة، ويزداد خطر الإصابة به عند السباحة في الأماكن الضحلة القريبة من الشاطئ. إنَّ الطريقة الأفضل لتجنُّب الإصابة به بالبقاء بعيداً عن المستنقعات التي تعيش فيها الحلزونات، لذا عليك دائماً الاستحمام بعد السباحة.
7. داء البريميات:

تتواجد البكتيريا المسببة لداء البريميات في مياه البحيرات والأنهار، وتصل إلى هذه المياه من خلال بول الحيوانات المصابة. تحصل الإصابة عند دخول الجرثومة عبر العينين أو الأنف أو الفم أو من خلال جرح في الجلد. وتتضمن الأعراض كلاً من الإسهال واحمرار العينين والصداع والحمَّى واليرقان (اصفرار الجلد أو العينين بسبب مشاكل في الكبد). ومن الشائع حدوث الإصابة في المناطق ذات الطقس الدافئ وبعد حدوث الأعاصير والفيضانات.
8. النيغلريّة الدجاجيّة:

تُسمَّى هذه العضيَّة الصغيرة المتواجدة في المياه العذبة مثل مياه البحيرات والأنهار والينابيع الدافئة بـ "الأميبا الآكلة للدماغ". وتحدث الإصابة بدخول هذه العضيَّة عبر الأنف عند السباحة في منطقة ملوثة، وبمجرد دخولها الجسم؛ تعمل على تدمير الأنسجة، وعادة ما تكون الإصابة قاتلة. تُعَدُّ الإصابات نادرة في الولايات المتحدة؛ فتوجد حوالي 3 إصابات سنوياً. ومن أجل تقليل خطر الإصابة قم بإغلاق أنفك عند السباحة، أو أبقِ رأسك خارج المياه عندما تسبح.
9. داء الضمّات:

إن قمت بالسباحة في إحدى المحيطات وكنت تعاني جرحاً ما أو خدشاً أو قمت بوضع وشم مؤخراً على جلدك، فإنَّك مُعرَّضٌ لدخول عديد من العضيَّات الصغيرة عبر الجرح مُتسبِّبة بإنتان لك. إحدى هذه العضيَّات هي ضمة الفالنيفيكوس، والتي تُسمَّى أحياناً بالجرثومة اللاحمة. إنَّها نادرة جداً ولكنَّها قد تسبب قرحةً جلديةً وعديداً من المشاكل الخطيرة الأخرى خاصة عند وجود ضعف مناعي لديك.
10. التهاب الملتحمة:

عندما يكون السبب جرثومياً؛ يصبح معدياً للغاية، لذا يمكن أن تُصاب عند سباحتك بنفس المياه التي سبح فيها شخص مصاب. تسبب هذه الإصابة (والتي تُدعى أحياناً بالعين الوردية) تورم العين واحمرارها ونزُّ سائلٍ أصفر منها. يمكن أن تحدث الإصابة نتيجة المواد الكيميائية أيضاً، فعلى سبيل المثال يمكن أن يسبب الكلور الموجود في المسابح التهاباً بسيطاً.
11. المواد الكيميائيّة:

إن أُصبت باحمرار العين أو تهيُّج الحلق أو السعال بعد السباحة في إحدى المسابح، فالسبب غالباً مادة الكلورامين. تتشكل هذه المادة عند اختلاط مواد كيميائية تُستخدم في تعقيم المسابح مع مفرزات الإنسان كالبول والبراز والعرق والجلد الميت. ويساعد الاستحمام قبل القفز إلى المياه (وعدم التبول في مياه المسبح) في الوقاية من هذه المشاكل.
تصرف وفق مبادئ الأمان عند السباحة:

يمكن لبعض النصائح الصحية أن تساعدك في الوقاية من هذه الأمراض، وتشمل هذه النصائح:
- ابق بعيداً عن المياه إن كنت مُصاباً بالإسهال.
- لا تسبح عند إصابتك بجرح ما، إلَّا في حال تغطية مكان الجرح بضماد مضاد للمياه.
- استحم قبل وبعد السباحة.
- ابق بعيداً عن المياه عند شمِّك رائحة مادة كيميائية قوية، أو إن بدت المياه رغوية وغير صافية.
أضف تعليقاً